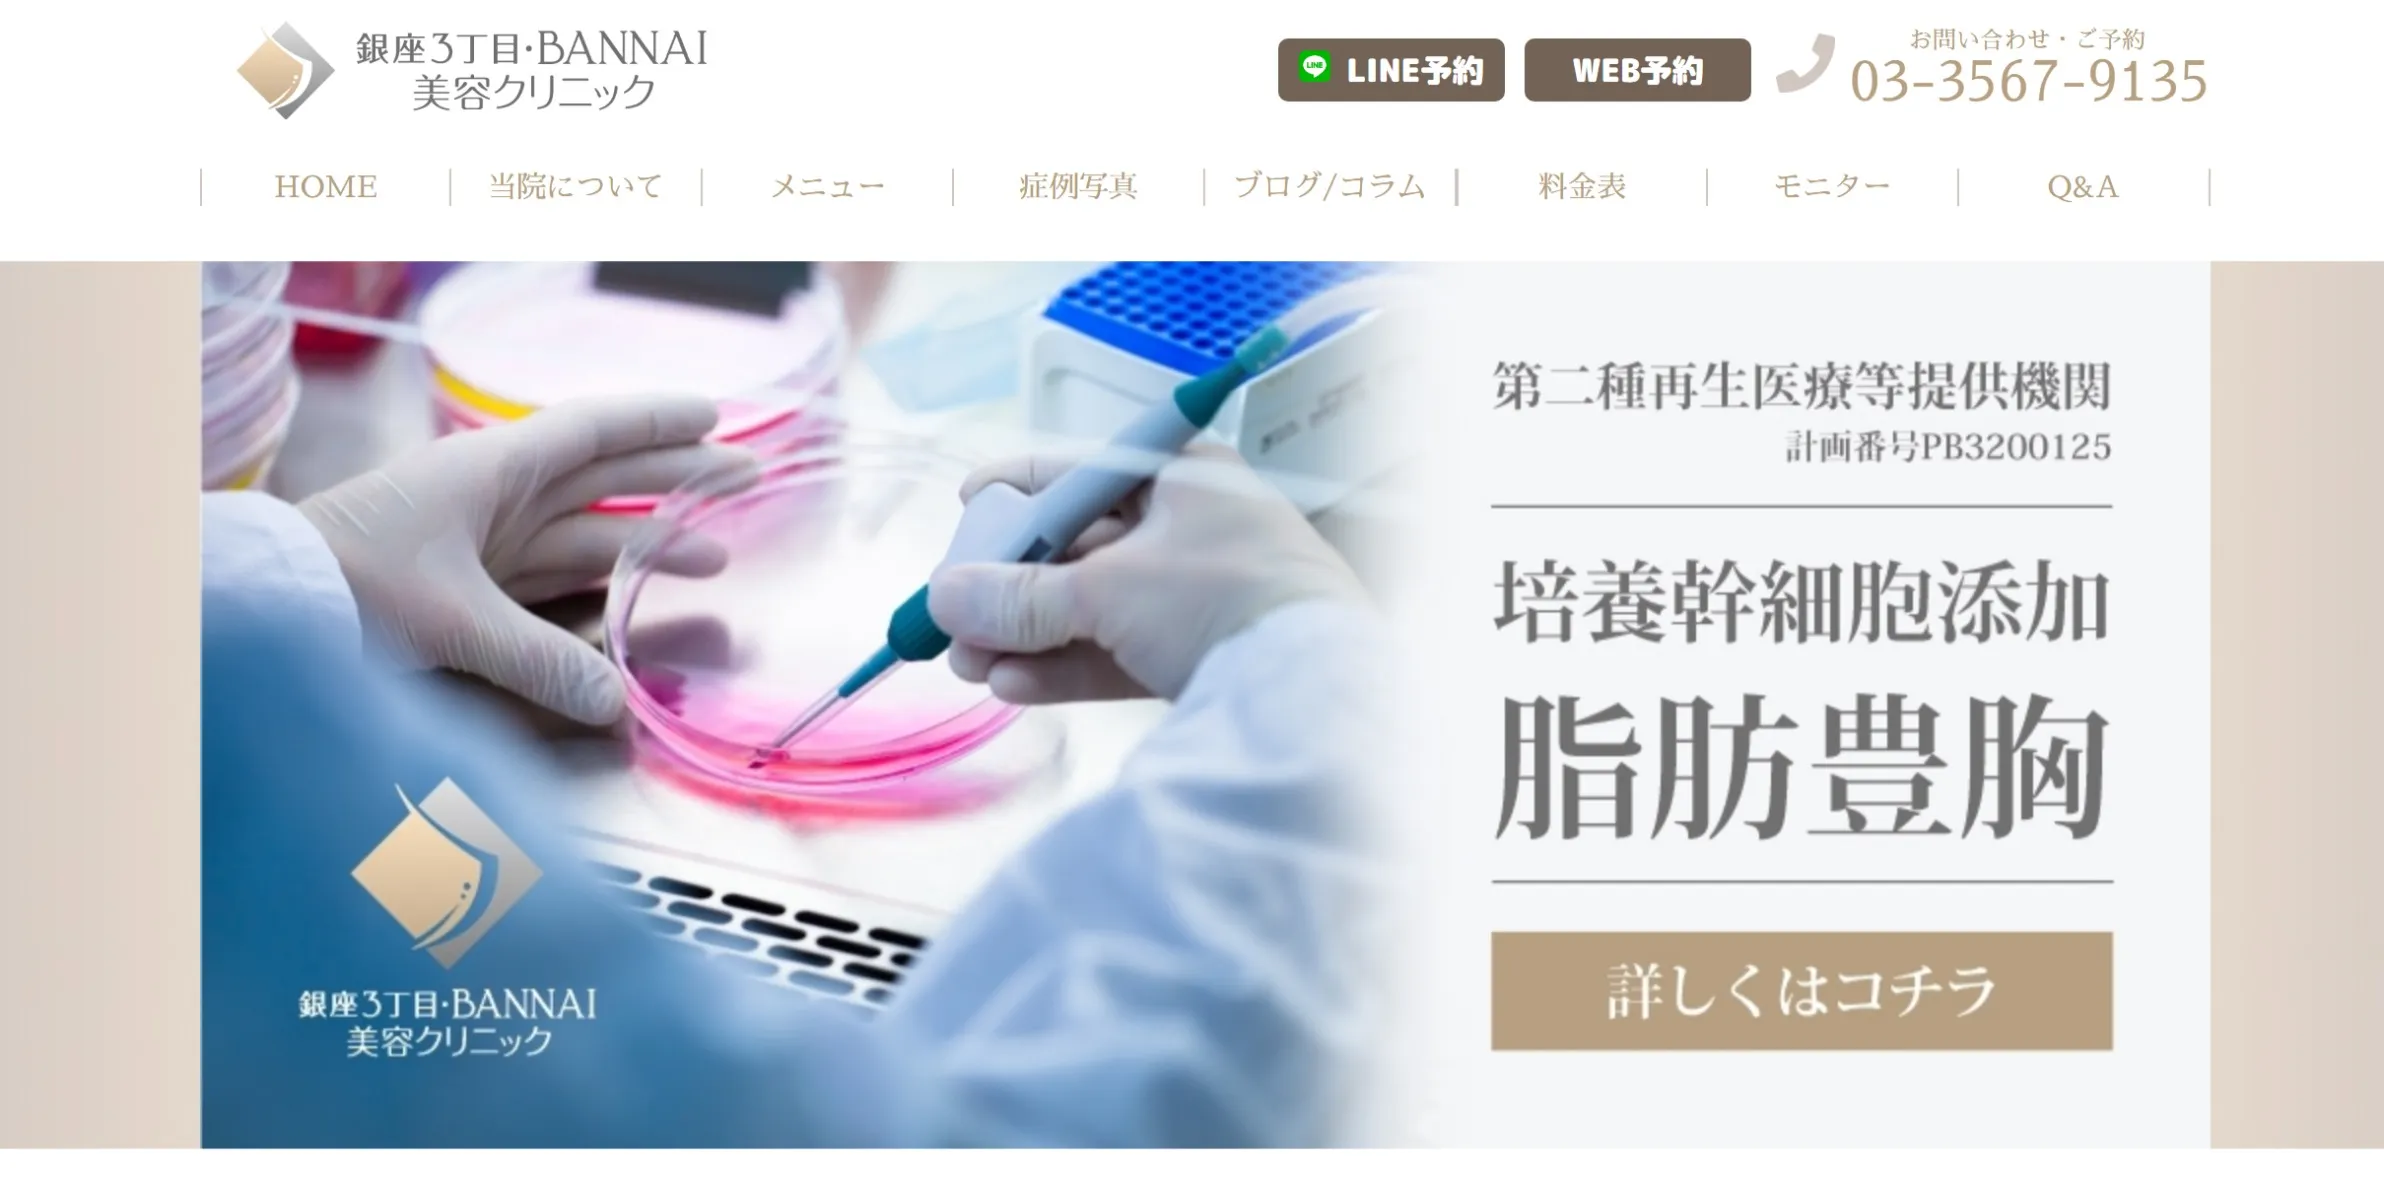
銀座３丁目・BANNAI美容クリニック

「小さな胸がコンプレックス」「授乳で胸のハリがなくなってしまった」このような悩みを解消してくれる方法の1つが、豊胸です。
しかし、東京エリアには数え切れないほどの美容クリニックがあります。カウンセリングに行きたくても候補を絞れない方も多いのではないでしょうか。
そこで今回は、東京で豊胸手術がおすすめのクリニックを比較形式でご紹介します。
クリニックの選び方、豊胸手術の種類についても詳しく解説しているため、東京で豊胸手術を検討している方はぜひ参考にしてみてください。
≫表は横スクロールします。
おすすめ
クリニック |
ガーデンクリニック |
THE CLINIC |
共立美容外科 |
東京美容外科 |
銀座3丁目BANNNAI
美容クリニック |
|
|
![]() |
![]() |
![]() |
![東京美容外科]()
|
![銀座3丁目BANNNAI美容外科]()
|
|
シリコン
バッグ
(税込)
|
\モニター料金/
1,100,000円〜
1,430,000円
|
1,089,000円~
|
608,300円~
|
550,000円
|
–
|
脂肪
注入
(税込) |
\モニター料金/
275,000円〜※
|
\モニター料金/
950,400円
1,133,000円
|
\モニター料金/
862,400円
1,232,000円
|
1,400,000円
|
\モニター料金/
613,000円
888,800円
|
症例
写真 |
instagram |
instagram |
instagram |
instagram |
instagram |
店舗
一覧 |
池袋/新宿/品川/船橋/横浜/名古屋/大阪/福岡 |
東京/名古屋/大阪/広島/福岡 |
札幌/仙台/銀座/横浜/大宮/柏/名古屋/梅田/広島/岡山/福岡 など
|
札幌/秋田/赤坂/新宿/高崎/名古屋/梅田/福岡 など
|
銀座 |
| 詳細 |
|
|
|
|
|
| 公式 |
|
|
|
|
|
≫表は横スクロールします。
| 🌟この記事のまとめ🌟 |
- 豊胸手術のクリニックを選ぶ時は実績豊富なドクターで選ぶべき
- 豊胸手術は主に「脂肪注入豊胸」「シリコンバッグ豊胸」の2種類
- 施術方法によってメリット・デメリットが異なるので自分の理想と合わせて決めるのが大切
- 東京で豊胸するなら23年の豊富な実績を持つ「ガーデンクリニック」がおすすめ!
|
この記事監修者
経歴・プロフィール
新潟大学医学部卒。同大学の一般消化器外科で勤務後、大手美容外科に10年以上所属し大型院院長やエリア統括を歴任。その間に脂肪豊胸手術のオリジナル注入方法であるプレミアム3D注入法を開発し、学会発表するとともに脂肪豊胸の年間手術件数NO.1になる。2020年3月に脂肪豊胸手術専門の銀座3丁目・BANNAI美容クリニックを独立開業。2023年5D注入法を開発し、現在に至る。
![坂本誠院長]()
東京で豊胸手術がおすすめのクリニック11選
ガーデンクリニック
THE CLINIC
共立美容外科
東京美容外科
銀座3丁目BANNAI美容クリニック
ヒアルロン酸
308,000円
60cc
180,000円
※60cc
198,000円
※60cc
-
-
シリコンバッグ
110,000円〜
※モティバ
1,089,000円~
ソフトバイオセルバッグ
608,300円
※モティバ
700,000円~
※モティバ
-
脂肪注入
550,000円〜
※ピュアグラフト
950,400円〜
※コンデンスリッチ
499,800円
※ピュアグラフト
1,400,000円
※シリコンバッグ+脂肪注入
613,000円〜
※コンデンスリッチ
クリニック数
8院
(池袋/新宿/品川 船橋/横浜/名古屋 大阪/福岡)
5院
(東京/名古屋/大阪 広島/福岡)
25院
(北海道/東北/関東 東海/関西/中国 四国/九州)
18院
(北海道/東北/中部/関東 近畿/中国/九州/沖縄)
1院
(銀座)
ガーデンクリニック
THE CLINIC
共立美容外科
東京美容外科
銀座3丁目BANNAI美容クリニック
ヒアルロン酸
308,000円
60cc
180,000円
※60cc
198,000円
※60cc
-
-
シリコンバッグ
110,000円〜
※モティバ
1,089,000円~
ソフトバイオセルバッグ
608,300円
※モティバ
700,000円~
※モティバ
-
脂肪注入
550,000円〜
※ピュアグラフト
950,400円〜
※コンデンスリッチ
499,800円
※ピュアグラフト
1,400,000円
※シリコンバッグ+脂肪注入
613,000円〜
※コンデンスリッチ
クリニック数
8院
(池袋/新宿/品川 船橋/横浜/名古屋 大阪/福岡)
5院
(東京/名古屋/大阪 広島/福岡)
25院
(北海道/東北/関東 東海/関西/中国 四国/九州)
18院
(北海道/東北/中部/関東 近畿/中国/九州/沖縄)
1院
(銀座)
≫表は横スクロールします。
≫東京で豊胸手術がおすすめのクリニック評価根拠はこちら。
≫東京で豊胸手術がおすすめのクリニック情報一覧はこちら。
※ヒアルロン酸豊胸についてメニューの記載を行っていますが、日本美容外科学会(JSAPS)においては推奨されていません。
ガーデンクリニック
![gardenclinic hokyo]()
ガーデンクリニックのおすすめポイント
- 【先着5名限定!】豊胸モニター募集中!顔出しなしOK!
- ライフスタイルに合わせた豊胸術を提案
- ボリュームアップ〜乳房再建まで幅広く対応
- 定期検診は一生涯無料!
- カウンセリングでの提示料金以外の追加費用なし
ガーデンクリニックは、創業23年を迎える実績豊富な老舗クリニックです。
脂肪吸引や豊胸術など美容施術のメニューを豊富に取り扱っており、豊胸に関しては3種類の施術法から選ぶことができます。
Recommend
そんなガーデンクリニックの注目したいポイントは、ライフスタイルに合わせた豊胸術を提案しているところです。
「会社を休めない」「小さな子供がいて忙しい」このようにダウンタイムの不安が大きい方も相談が可能です。
なお、ガーデンクリニックは、バストのボリュームアップだけでなく乳房再建術にも対応しています。
幅広い悩みに合わせて、一人ひとりに合った施術を提供しているのが大きな強みと言えるでしょう。
カウンセリングで提示した料金以外の費用は一切発生しないため、予定外の費用が発生する心配が少ないのもうれしいポイントです。
| 料金(税込) |
【シリコンバック】
Motiva(モティバ):1,100,000円
【脂肪注入】
LFD脂肪注入豊胸:275,000円+脂肪吸引代
ピュアグラフト豊胸:330,000円(税込)+脂肪吸引代
コンデンスリッチ豊胸:1,320,000円(税込) ※脂肪吸引代込
※脂肪吸引代:220,000〜660,000円(税込)
|
| カウンセリング |
無料 |
| 営業時間 |
10:00~19:00 |
| 所在地 |
池袋・新宿・品川 |
出典:ガーデンクリニック
ガーデンクリニック 池袋院の口コミ
![]()
豊胸施術者
柴田先生がご担当で他のカウンセラーさんや看護師さんからも柴田先生なら安心して手術をしてくださるという情報をいただいていました。全くその通りで優しくお話ししてくださり、また確実な施術をしていただいたおかげで、満足のいく体になってきました。
-GoogleMap(一部抜粋)
![]()
豊胸施術者
今回友人に紹介してもらい柴田先生に脂肪豊胸オペしていただきました。友達が仕上がりに満足という話を聞いていて気になっていたので脂肪豊胸選んだのですが友達の言うとおり胸も大きくなってボリュームが出てきて、露出する時期がとても楽しみです、本当にありがとうございます。
-GoogleMap(一部抜粋)
![]()
豊胸施術者
初めての整形手術だったので不安だらけでしたが、カウンセリングから術後経過まで本当にとても丁寧に診察していただけてよかったです!
ダウンタイム中も痛みはほとんど無く、わからないことはすぐにお電話で対応していただけて安心でした。-GoogleMap(一部抜粋)
※記事内で紹介されている口コミは個人の感想であり、効果や身体の安全性その他の事項を保証するものではありません。効果には個人差があります。
THE CLINIC
![theclinic hokyo]()
THE CLINICのおすすめポイント
- 【先着5名限定】脂肪注入豊胸モニター募集中!
- 脂肪注入での豊胸でナチュラルに仕上げる
- 技術指導経験のある優秀な医師多数在籍
- 難易度の高い失敗修正も可能!
- シコリができにくい脂肪注入
THE CLINICは東京に1院展開しており、脂肪注入を中心とした豊胸施術を受けることができます。
Recommend
現在は顔出しをせずに、通常よりも安い料金でお悩みや理想に合わせた豊胸を行うモニター施術を受け付けています。
こちらのモニターはカウンセリングや麻酔、術後のケアまで込みとなっており安心して施術を受けていただけます。
国内の医師に技術指導を行うなど経験豊富な医師が在籍しているため、他院での失敗を修正する治療も可能となっています。
東京では豊胸施術を行なっているクリニックが多数ありますが、中には仕上がりの満足度が低い方もいるかもしれません。THE CLINICではそういった方のために豊胸の修正外来を設けており、おすすめです。
| 料金(税込) |
【シリコンバッグ】
ソフトバイオセルバッグ:825,000円
【脂肪注入】
コンデンスリッチ豊胸:950,400円〜
ピュアグラフト豊胸:528,000円〜
コンデンスセルチャー豊胸:1,914,000円
コンデンスビブラ豊胸:1,353,000円
エクソソーム豊胸:1,287,000円
|
| カウンセリング |
無料 |
| 営業時間 |
10:00~19:00(完全予約制) |
| 所在地 |
東京(西麻布) |
出典:THE CLINIC
THE CLINICの口コミ
![]()
豊胸施術者
元々Aカップで貧乳でしたが、1カップは確実に大きくなった事と、膨らみが出来て形が綺麗になった事がとても嬉しいです。また、何十年もコンプレックスだった二の腕がほっそりしたので、ノースリーブや好きなお洋服を着られる事が楽しみです。-GoogleMap(一部抜粋)
![]()
豊胸施術者
脂肪豊胸をお願いしました。
左右や胸の大きさの出来上がりにとても満足しました。
綺麗に仕上げてくださってありがとうございます。-GoogleMap(一部抜粋)
![]()
豊胸施術者
3ヶ月たった今、下着を新たに購入しに行き、サイズを測りましたが脂肪豊胸をする前がB65でしたが今回2度目の脂肪豊胸後でD70まで
サイズアップしていました。感動です。-GoogleMap(一部抜粋)
※記事内で紹介されている口コミは個人の感想であり、効果や身体の安全性その他の事項を保証するものではありません。効果には個人差があります。
共立美容外科
![共立美容外科]()
共立美容外科のおすすめポイント
- 最大40%OFF!新宿・渋谷院でそれぞれモニター募集中
- 東京に5院展開するクリニック
- 7種類以上の施術方法を用意
- 開院から30年以上の経験と技術
共立美容外科は東京に5院展開しており、通いやすいクリニックとなっています。
Check Point
現在、新宿院では脂肪注入法のコンデンスリッチのモニターを最大30%OFFで募集しています。
更に渋谷院では全ての豊胸施術を10〜40%OFFの価格で提供するモニターも募集しているので、気になる方はぜひチェックしてみてください。
共立美容外科ではお客様の体の状態に応じて、7つ以上の施術法から最適な施術方法を選ぶことができます。
30年以上豊胸に関する技術を磨いてきた経験を活かして、丁寧なヒアリングを行なっており、経験豊富な医師をお探しの方におすすめです。
| 料金(税込) |
【シリコンバッグ】
生理食塩水バッグ:398,200円
メモリージェルバッグ:608,300円
モティバ エルゴノミックス:792,000円
(エルゴノミックスタイプ)
モティバ:608,300円
(エルゴノミックスではないタイプ)
KUJIME式ダブルトリートメント豊胸術:
第1オペ ¥1,049,400
第2オペ ¥632,500
【脂肪注入】
コンデンスリッチ豊胸術:1,232,000円
ピュアグラフト50: 199,800円
ピュアグラフト50 ¥199,800円
ピュアグラフト250 ¥499,800
ピュアグラフト400 ¥599,800
ピュアグラフト850 ¥799,800
|
| カウンセリング |
無料 |
| 営業時間 |
10:00~19:00(完全予約制) |
| 所在地 |
新宿・銀座・渋谷・池袋・立川 |
出典:共立美容外科
共立美容外科 渋谷院の口コミ
![]()
豊胸施術者
あざや内出血も綺麗に消えて無くなり、傷も綺麗に徐々に治ってきました!
胸のほうもすごく綺麗でかなり満足な仕上がりにしてくれました!-GoogleMap(一部抜粋)
![]()
豊胸施術者
痩せ型体型でしたが、全部の悩みを見ただけで組んで下さり、違和感なく仕上げて貰えて感動でした!😭
カウンセリングも看護師の方も全員優しく不安な事など先生にも何度も相談可能でしたのでとても安心して施術をお願い出来ました!
-GoogleMap(一部抜粋)
![]()
豊胸施術者
今術後1ヶ月ですが、あざや内出血も綺麗に消えて無くなり、傷も綺麗に徐々に治ってきました!胸のほうもすごく綺麗でかなり満足な仕上がりにしてくれました!-GoogleMap(一部抜粋)
※記事内で紹介されている口コミは個人の感想であり、効果や身体の安全性その他の事項を保証するものではありません。効果には個人差があります。
東京美容外科
![tokyobiyougeka houkyo]()
東京美容外科のおすすめポイント
- モニター施術で50%OFF
- 出血・痛みの少ない技術力!
- 傷跡が目立ちにくい豊胸施術!
- 生涯アフターケアで薬や検査費が無料
東京美容外科では、麻生泰総括院長が考え出した新たな豊胸施術を行なっていて、非常に好評なものとなっています。
Check Point
従来のシリコンバッグとは異なり、カニューレを通すことで出血や痛みを抑え、硬くなりにくい施術を可能としています。
切開部位は最小限ですので、傷跡も目立ちにくいことからもおすすめです。
施術では必ず麻酔のプロが全身麻酔を使い、執刀医は手術に集中できる環境を作っているため、患者にも医師にも配慮した施術が行われています。
一度豊胸施術を受けると、処方薬や検査費が無料となり、乳がんの検査なども1回無料で行うことができるなど、アフターケアも充実しています。
| 料金(税込) |
【シリコンバッグ】
1カップUP:550,000円
2カップ以上UP:950,000円
ペアル:150,000円
Motiva エルゴノミクス2:150,000円
ベラジェル スムースファイン:150,000円
【ハイブリッド】
シリコンバッグ+脂肪注入:1,400,000円
|
| カウンセリング |
無料 |
| 営業時間 |
9:00~21:00 |
| 所在地 |
赤坂・銀座・新宿・池袋 |
出典:東京美容外科
東京美容外科 新宿院の口コミ
![]()
豊胸施術者
看護師さんやスタッフの方々もとても親切で安心して毎回通えています。
麻酔科の先生もとても優しくて手術時にとても安心できました。
術後1週間ですが痛みも引いてきて仕上がりが楽しみです!-GoogleMap(一部抜粋)
![]()
豊胸施術者
エクスパレル効果もあり、施術当日から激しい痛みもなく普段の生活も仕事も無理なく可能で感動しました。
術後2ヶ月以降から少しずつ下垂もしてきて柔らかくもなっています。
清潔感ある院内で冨田先生も看護師さんも丁寧に話を聞いてくれるので私はここに決めて本当に良かったと思っています。綺麗な胸をありがとうございました。
-GoogleMap(一部抜粋)
![]()
豊胸施術者
冨田先生にシリコンバック豊胸をしていただきました。看護師さんやスタッフの方々もとても親切で安心して毎回通えています。-GoogleMap(一部抜粋)
※記事内で紹介されている口コミは個人の感想であり、効果や身体の安全性その他の事項を保証するものではありません。効果には個人差があります。
銀座3丁目・BANNAI美容クリニック
![銀座3丁目・BANNAI美容クリニック]()
銀座3丁目・BANNAI美容クリニックのおすすめポイント
- 脂肪注入豊胸術に特化
- 少ない脂肪で立体感を出す5D注入法を採用
- 脂肪豊胸手術3,800件以上の実績(2024年12月現在)
- 脂肪豊胸年間300件以上(2022年〜)
- リピーター割で最大20万円お得
- 再手術が無料になる「サイズ保証」制度あり
銀座三丁目・BANNAI美容クリニックは、脂肪注入による豊胸術に特化したクリニックです。
お腹や太ももから吸引した脂肪を使い、理想のバストサイズを実現することができます。
部分痩せと同時にバストアップが可能となるため、体型が気になっている方には一石二鳥の施術法だと言えるでしょう。
Recommend
さらに注目したいのは、少ない脂肪でも美乳に必要な立体感を演出する5D注入法を採用しているところです。
BMI15未満の痩せている方でも脂肪注入による豊胸が実現するのは、銀座3丁目・BANNAI美容クリニックならではと言えるでしょう。
脂肪豊胸手術3,800例以上の実績ある院長が、最初から最後まで責任を持って対応を行います。
なお、銀座3丁目・BANNAI美容クリニックでは、最大20万円お得になるリピーター割を実施中です。2回目以降のオプション料金が半額になります。
規定のサイズに満たなかった場合には、サイズ保証制度によって再手術が無料※です。
| 料金(税込) |
【脂肪注入】
クリスタルセット
(ウルトラZ併用 アキーセル脂肪吸引+5D注入法併用ピュア脂肪注入+麻酔代)
1,463,000円
(モニター:935,000円)
ブロンズセット
(ウルトラZ•シリンジ法併用 脂肪吸引+5D注入法併用コンデンスリッチ脂肪注入+麻酔代)
2,230,800円
(モニター:1,398,000円)
|
| カウンセリング |
初診料:5,000円
|
| 営業時間 |
09:00~18:00 |
| 所在地 |
銀座 |
出典:銀座3丁目・BANNAI美容クリニック
※適用の条件等の詳細につきましては、公式サイトをご確認いただきますようお願いいたします。
銀座3丁目・BANNAI美容クリニックの口コミ
![]()
豊胸施術者
前回は太ももから、今回は二の腕からの脂肪豊胸をお願いしました。
バストはもちろんですが、脂肪吸引した箇所が本当に綺麗で、毎回大満足の仕上がりです!-GoogleMap(一部抜粋)
![]()
豊胸施術者
カウンセリングや手術の際のスタッフの皆様は丁寧で、手際の良さが素晴らしく、不安に思う事等全てお話しして手術に臨む事ができました。手術後は打撲のような痛みが脂肪吸引部にありましたが、胸の痛みはほぼ無かったです。
-GoogleMap(一部抜粋)
![]()
豊胸施術者
たくさんのクチコミにもあるように、なにより先生がとても優しく親しみやすいです。雰囲気から優しいので質問もしやすいし、経過観察の度に褒めてくれますし、自信に溢れていて安心感がありました。-GoogleMap(一部抜粋)
美容外科シンシア
![美容外科シンシア豊胸LP]()
美容外科シンシアのおすすめポイント
- カウンセリングは医師のみ対応
- 再施術が無料となる保証制度を導入
- 初診・再診料が無料
シンシアは、カウンセラーではなく医師がカウンセリングを担当するクリニックです。
時間をかけた丁寧なカウンセリングでは、悩みや不安の相談はもちろん豊胸術のメリット・デメリットについて詳しく説明を受けられるでしょう。
Recommend
さらに注目したいのは、保証制度を導入しているところ。万が一やり直しが必要と医師が判断した場合には、無料で再施術を受けることが可能です。
自由診療である豊胸については、初診・再診ともに診察料は無料。余計なコストを抑えてお得に施術を受けられるのもうれしいポイントです。
| 料金(税込) |
【脂肪注入】
コンデンスリッチファット豊胸
660,000円:+各部位脂肪吸引代
(各部位ごとの脂肪吸引料金に加算)
|
| カウンセリング |
無料 |
| 営業時間 |
10:00~20:00 |
| 所在地 |
銀座・渋谷 |
出典:美容外科シンシア
美容外科シンシア 銀座院の口コミ•評判
![]()
利用者
デメリットも丁寧にご説明いただけて、その結果施術をやめると伝えても引き止められることもなく、とても信頼できます。 銀座院も渋谷院も医師に直接きちんとカウンセリングしていただけて、謎のカウンセラーからの強要は一切ありません。-GoogleMap(一部抜粋)
![]()
利用者
受付の方の対応も凄く丁寧で、カウンセリングも先生と1対1で行います。一つ一つ、メリット・デメリットを事細かく説明してくれて、よくある美容外科の高いプランを勧めてくるなどは一切ありません。-GoogleMap(一部抜粋)
※記事内で紹介されている口コミは個人の感想であり、効果や身体の安全性その他の事項を保証するものではありません。効果には個人差があります。
宮益坂クリニック
![宮益坂クリニック]()
宮益坂クリニックのおすすめポイント
- キャリア20年以上の形成外科専門医が在籍
- 乳房の変形・しこりリスクの少ない術式を採用
- 乳房再建など幅広い手術に対応
- LINEの追加で限定クーポンがもらえる
宮益坂クリニックは、渋谷駅から徒歩7分のエリアにある美容クリニックです。
キャリア20年以上の形成外科専門医である院長が、術後の回復や感染リスクを考慮しながら丁寧な施術を行っています。
そんな宮益坂クリニックで受けられる豊胸手術は、脂肪注入またはシリコンバッグの挿入です。
Recommend
乳房の変形はもちろん、しこりリスクを抑えた術式を採用しています。
豊胸のほか乳房再建や乳頭縮小などの幅広い胸整形に対応しているため、様々なお悩みの解消につながるでしょう。
丁寧なアフターケアを心がけており、日常ケアのアドバイスや術後の経過観察も積極的に行っています。
LINE公式アカウントでお得な限定クーポンも配信しているため、お得に施術を受けたい方は要チェックです。
| 料金(税込) |
【シリコンバッグ】:660,000円
※シリコンバッグ種類未記載
【脂肪注入】
(片側100ml・両側で200mlまで):880,000円
(片側150ml・両側で300mlまで):1,100,000円
(制限なし):1,540,000円
|
| カウンセリング |
初診料:3,300円 |
| 営業時間 |
10:00~19:00 |
| 所在地 |
渋谷 |
出典:宮益坂クリニック
ロシッククリニック銀座
![ロシッククリニック銀座]()
ロシッククリニック銀座のおすすめポイント
- 豊胸・鼻の整形に特化したクリニック
- 豊胸術の症例数が年間300例以上※1
- ダウンタイムに配慮した完全直視下法を導入
- 術後の痛み・出血を極限まで抑えることが可能
- ナチュラルなボリュームのバストを実現可能
銀座1丁目駅から徒歩1分の好立地にあるロシッククリニックは、豊胸と鼻の整形に特化した美容専門のクリニックです。
豊胸術では国内屈指の症例数を誇る院長が在籍しており、年間300例以上※1の実績があります。
そんなロシッククリニックのおすすめポイントは、院長が考案した完全直視下法を導入しているところです。
Recommend
医学誌も認める完全直視下法の豊胸術は、従来までの施術法では難しいミリ単位の調整が可能。
痛みや出血を極限まで抑えることが可能なため、できるだけダウンタイムを短くしたい方にもおすすめです。
さらに、ロシッククリニックの豊胸術で注目したい大きなポイントは、ナチュラルなバストアップを実現可能なところ。
要望や体型に合わせて、専門医師の視点から適したサイズの提案を受けられます。
| 料金(税込) |
【脂肪注入】:880,000円+脂肪吸引代
【シリコンバッグ】
完全直視下・乳腺下法:1,155,000円
完全直視下・デュアルプレーン法:1,595,000円
【ハイブリッド】:1,595,000円
|
| カウンセリング |
無料 |
| 営業時間 |
10:00~19:00 |
| 所在地 |
銀座 |
出典:ロシッククリニック
※1:前職(東京美容外科 新宿院院長)実績
有楽町高野美容クリニック
![有楽町高野美容クリニック]()
有楽町高野美容クリニックのおすすめポイント
- JR有楽町駅から徒歩3分の通いやすい立地
- 形成外科専門医による丁寧なカウンセリング
- FDA承認の安全性を重視した・リアルな質感のシリコンバッグ
- 術中・術後の痛みにしっかりと配慮
JR有楽町駅から徒歩3分の立地にあるのが、有楽町高野美容クリニックです。
日本形成外科学会の専門医である院長がカウンセリングを行い、悩みや希望を丁寧にヒアリングしたうえで施術の提案を行っています。
Recommend
注目したいおすすめポイントは、FDAが承認している安全性を重視したシリコンバックを使用しているところです。
質感もリアルなため、不自然な仕上がりになることに不安がある方も安心して足を運びやすいでしょう。
さらに、有楽町高野美容クリニックでは、患者に苦痛を与えない安全性を考えた施術を第一に考えています。
術中や術後の痛みにもしっかりと配慮している点は、施術を受けるうえでうれしいポイントの1つです。
| 料金(税込) |
【シリコンバッグ】
Motiva経乳房下溝:825,000円
Motiva経腋下:880,000円
|
| カウンセリング |
初診料:3,300円 |
| 営業時間 |
【平日】
11:00~14:30
15:30~20:00
【土日祝】
11:00~13:30
14:30~18:00
|
| 所在地 |
有楽町 |
出典:有楽町高野美容クリニック
東京イセアクリニック
![東京イセアクリニック]()
東京イセアクリニックのおすすめポイント
- 国内で数少ない日本形成外科学会の連携施設
- 症例写真が豊富
- 幅広い胸の悩みに対応
東京イセアクリニックは、美容外科では全国に11施設しかない日本形成外科学会の連携施設に認定されているクリニックです。
Recommend
公式サイトでは症例写真が豊富に掲載されているため、仕上がりをイメージしやすいのもうれしいポイントです。
また、下がり気味のバストを引き上げる「乳房吊り上げ術」にも対応しています。
胸が小さいとお悩みの方はもちろんのこと、左右差がある・加齢で下がってきたといった悩みにも、あわせて幅広く対応してもらえるでしょう。
| 料金(税込) |
【シリコンバッグ豊胸】
バッグ除去なし:935,000円
|
| カウンセリング |
無料 |
| 営業時間 |
11:00~20:00 |
| 所在地 |
新宿 |
出典:東京イセアクリニック
オーキッド美容クリニック東京御徒町
![オーキッド美容クリニック東京御徒町]()
オーキッド美容クリニック東京御徒町のおすすめポイント
- 形成外科専門医が担当
- 女性の悩みに特化した施術メニューが豊富
- お試し価格でお得に施術が可能
- LINEから24時間予約が可能
コンデンスリッチ豊胸術を取り扱うオーキッド美容クリニック東京御徒町は、形成外科専門医が施術を担当するクリニックです。
お腹や太ももから自身の脂肪を採取し、良質な脂肪細胞のみを豊胸に使用します。さらに注目したいのは、女性のお悩みに特化した施術メニューが豊富な点です。
Recommend
3つの豊胸施術メニューのほか、スキンケアや部分整形など幅広く美容施術を取り扱っています。
豊胸と同時にあらゆる悩みを相談できるのは、オーキッド美容クリニック東京御徒町の大きなメリットと言えるでしょう。
なお、シリコンバッグ豊胸やコンデンスリッチ豊胸術は、通常よりもお得な価格で施術が受けられるお試し価格の用意があります。希望する方は、カウンセリング時に要望を伝えましょう。
クリニックの公式LINEアカウントを友達追加しておけば、24時間予約が可能なのも嬉しいポイントです。
| 料金(税込) |
【シリコンバッグ】
858,000円~
【脂肪注入】
CRF脂肪注入:935,000円
(お試し価格:704,000円)
|
| カウンセリング |
無料 |
| 営業時間 |
10:00~18:30 |
| 所在地 |
上野 |
出典:オーキッド美容クリニック東京御徒町
東京で豊胸手術を受けるクリニックの選び方
豊胸手術で高い満足度を得るためには、ドクター選びが重要です。
「高額な費用を支払ったのに満足できなかった」と後悔する結果にならないためにも、ドクターの豊胸手術の実績や症例数、症例写真を確認しましょう。
豊胸は見た目形や美しさだけでなく、左右のバランスや触感、術後の安全性も求められる繊細な手術です。
Recommend
つまり、医師の腕によって仕上がりが大きく左右されるので、ドクター選びは慎重に行う必要があります。
豊胸手術の経験が豊富なドクターであれば、さまざまな悩みや体型の人の手術しているため、自分の体型に合わせた手術を施してくれます。
そのため豊胸手術による失敗やトラブルを防ぐことができ、理想のバストが手に入るでしょう。
公式サイトやSNSなどで症例写真を確認することも大切です。
【東京】豊胸手術にはどんな施術方法がある?
豊胸手術には、いくつかの施術方法があります。主な方法として挙げられるのは「脂肪注入」「シリコンバッグ」の2種類です。
(「ヒアルロン酸注入豊胸は2022年日本美容外科学会にて推奨されていないため不記載)
どの方法を選ぶかによって、見た目の仕上がり・触ったときの質感・持続期間などが異なるため、それぞれの特徴について順番に確認していきましょう。
脂肪注入豊胸
脂肪注入豊胸は、身体の脂肪吸引から施術がスタートします。比較的脂肪が多い太ももやお腹部分から脂肪を採取し、バストに注入する豊胸術です。
コンデンスリッチファット法では、採取した脂肪から不純物を取り除くため遠心分離器にかけ、濃縮した脂肪細胞を注入します。
Recommend
脂肪を使用していることから、本物のバストのような自然な柔らかさを目指すことが可能です。
ただし、もともと痩せ型の人は必要な量の脂肪が採取できず施術を受けられない可能性があります。
また、脂肪吸引をした部位には筋肉痛のような痛みが生じ、内出血が1ヶ月程度残ることがあります。
出典:表参道スキンクリニック
シリコンバッグ豊胸
シリコンバッグ豊胸は、ジェルが入ったシリコン製のバッグを胸に挿入する豊胸術です。
要望に合わせてサイズが自由に決められるため、大幅なバストアップを希望する方に向いているでしょう。
Recommend
触ったときの質感は皮下脂肪の量で変化します。脂肪が少ない人は天然のバストよりも若干硬く、脂肪が多い人は柔らかく感じられるでしょう。
自然な質感を求める場合は、体型に合った大きさのシリコンバッグを選ぶことが重要です。
一方で、体型によっては不自然な仕上がりになったり、年齢を重ねることで形のバランスが崩れてしまう可能性もあります。
とにかく自然な仕上がりを目指したいという場合は注意が必要です。
出典:セルバンク
【東京】豊胸手術の施術法別メリット・デメリット
豊胸手術は、施術法によってそれぞれ様々なメリット・デメリットがあります。
ここでは「脂肪注入豊胸」「シリコンバッグ豊胸」のメリット・デメリットについて解説していきます。
脂肪注入豊胸のメリット・デメリット
| メリット |
デメリット |
・大きな傷跡が残りにくい
・持続期間が長い
・自然な仕上がりと質感
・安全性が高い |
・部分痩せができる反面脂肪吸引部位もダウンタイムがある
・費用が高め |
脂肪注入豊胸のメリットは、バスト周辺に大きな傷跡が残らなかったり、持続期間が長かったりする点です。
脂肪が定着した後は、長期にわたってバストアップ効果が持続します。また、触った感じの質感も比較的自然です。
Recommend
自分の脂肪を使って施術を行うため、乳がん再発などの安全面への心配も抑えるよう配慮されています。
一方で、太ももやお腹から脂肪を吸引する必要があるため、胸だけでなく脂肪吸引施術をした部位にもダウンタイムがあり、部分痩せも同時にできますが、気軽な施術とはいえないのがデメリットです。
また、豊胸と痩身が同時にできるため、費用が高めなのがネックに感じる人も少なくありません。
出典:THE CLINIC
シリコンバッグ豊胸のメリット・デメリット
| メリット |
デメリット |
・体型関係なくバストアップ可能
・大幅なサイズアップが実現可能
・ハリ感や弾力を出せる
・形が選べる |
・ダウンタイム期間が長め
・体内に異物が挿入される
・傷が数センチとやや大きめ
•破損のリスクもあり入れ替えを考慮する必要もある
|
シリコンバッグ豊胸のメリットは、体型を気にすることなくバストアップが実現する点です。
痩せている人でも大幅なサイズアップが可能なため、理想の仕上がりが1度の手術で手に入る方も少なくないでしょう。
Recommend
授乳や加齢で胸が小さくなってしまった場合も、ハリ感・弾力を出すことが可能です。
また、仕上がりに合わせて形を選べたり、1度でも大幅なサイズアップが可能だったりするのも魅力的なポイントと言えるでしょう。
一方、デメリットとしては術後のダウンタイムが挙げられます。痛みや腫れが強く出る場合もあるため、気軽な施術だとは言えません。
また、体内に異物が挿入されるシリコンバッグ豊胸は、マンモグラフィーなどの乳がん検査を受けられない場合もあります。
シリコンバックの経年劣化を考えて、入れ替えなどメンテナンスが必要だったり挿入する際に数センチの傷が残りやすかったりするのも、マイナスポイントとして挙げられるでしょう。
胸の大きさや形を最重視する方に適した施術方法といえます。
出典:湘南美容クリニック
【東京】豊胸手術をするまでに知っておくべきこと
豊胸手術は安価で行える美容整形ではありません。そのため、手術を受ける前に入念な下調べが必要であるといえます。
ここでは、豊胸手術をする前に知っておくべきことについて解説していきます。
手術までの体調管理
手術当日までの体調管理は徹底的に行いましょう。睡眠不足や体調不良は麻酔に悪影響がでる可能性があるので危険です。
そのため、「眠りにつけなかったらどうしよう・・・」という不安から睡眠不足の状態で手術当日を迎えるのは控えましょう。
緊張せず、当日は万全な体調で手術を受けられるようにしましょうね。
また、麻酔の種類にもよりますが、施術直前の食事は控えた方が良いでしょう。
自分自身がリラックスできる服を着て、クリニックへ向かうのがおすすめです。麻酔を使用するので、自動車を運転してクリニックを訪れることは絶対にやめてください。
施術のリスク
豊胸手術全体に共通するリスクとして「しこり」があげられます。シリコンバッグを含め、しこりのリスクがゼロの豊胸手術はありません。
「しこり」は体内に人工物が入ることで自然発生してしまうリスクのある症状です。
しかし、適切な技術を持つクリニックにおいてはそのリスクを最小限に抑えることが可能です。
そのため、手術前に行うカウンセリングで、「しこり」やその他の手術に伴うリスクについて担当医に直接話を聞くことが肝心です。
疑問に感じている箇所、不安点などは施術前になるべく解消しておくことをおすすめします。
アフターケア
豊胸手術は施術後、最低でも1週間はダウンタイム期間があります。
しかし、施術後3ヶ月、4ヵ月と時間が経っても胸に違和感や痛みが残る場合には、医師への相談が必要です。
Recommend
術後の違和感を自己判断で放置してしまうのは危険です。乳房の病気である可能性もあるため、すぐに医師に相談しましょう。
そのため、施術後にも定期的に病院に通院することがおすすめです。
少しでも手術後の体調に違和感を感じた場合は、担当の医師に直接相談してみると良いでしょう。また、施術を受けたクリニックに不信感を感じた場合は、迅速に別の病院でセカンドオピニオンを求めましょう。
【東京】豊胸手術までの流れ
| 脂肪注入豊胸 |
シリコンバッグ豊胸 |
- カウンセリング
- 麻酔
(全身麻酔、硬膜外麻酔、静脈麻酔など)
- 脂肪吸引
- 脂肪注入
- アフターケア
|
- カウンセリング
- 麻酔
(全身麻酔、硬膜外麻酔、静脈麻酔など)
- 挿入口切開
- シリコンバッグ挿入
- 傷口の縫合
- アフターケア
|
豊胸手術までの流れは、どの方法で豊胸するかによって変わります。
「脂肪注入豊胸」「シリコンバッグ豊胸」それぞれの主な流れは上記の表のとおりです。
Recommend
脂肪注入豊胸とシリコンバッグ豊胸に関しては、手術が始まる前に全身麻酔をかける場合もあります。
前日の夜、または当日の朝から絶食になる可能性があるため、クリニックの指示に従って手術の前準備をしておく必要があります。
具体的な流れや必要な準備等はクリニックにより異なります。カウンセリング時にしっかりと確認しておきましょう。
出典:豊胸 浜松中央クリニック
東京での豊胸手術でよくある質問
豊胸手術の平均価格は施術方法によって異なります。シリコンバッグ豊胸は約50〜100万円、脂肪注入は約50〜150万円といわれています。クリニックによっても施術料金に差があるので様々なクリニックを比較してみることがおすすめです。
豊胸手術をすると術直後から2週間くらいの間で胸の痛みや内出血が起きる場合があります。1ヶ月ほど経つとこれらの症状は落ち着くことが多いです。安定するまでは体を清潔に保ったりなるべく形を安定させるように努めましょう。
豊胸手術は基本的に、挿入・除去ともに保険適用外の治療です。乳房再建手術では健康保険が適用されますが、豊胸手術は美容目的の施術とみなされるためです。
身体が老化するにつれて豊胸した胸にもサイズダウンや冷え、バッグが目立つなどの変化が現れます。老後も美しい胸を保つためには自分にあうクリニックで無理のない施術を受けることや日々ナイトブラなどの胸のケアを続けることが大切です。
おすすめのクリニックは「ガーデンクリニック」です。術後のアフターケアをしっかり行ってもらえて定期検診が一生涯無料なので、安心して通えるでしょう。またアフターケア代含む施術は月々3,800円〜受けられるので、良心的な金額もおすすめするポイントの1つです。
東京のクリニックで豊胸の脂肪注入できるところはどこ?
当記事で紹介する東京のクリニックでは「有楽町高野美容クリニック」「東京イセアクリニック」以外すべてのクリニックが脂肪注入施術方法を採用しています。脂肪注入のメリットは太さが気になる部位から脂肪分を取り、その脂肪分を豊胸に当てられることです。
豊胸修正でおすすめのクリニックは「東京美容外科」です。他院で行った豊胸手術修正は年間250件以上あり、医療事故は20年間0件の実績を誇ります。歴の長さや実績面では比較的安心できますが、まずは状態を医師に相談するのがよいでしょう。
東京の豊胸手術おすすめクリニック11選まとめ
今回は、東京エリアの豊胸におすすめのクリニックと、施術方法の違いやクリニックの選び方などについて紹介しました。
豊胸手術は、クリニック選びが重要です。本記事内で紹介した選び方のコツを参考にしながら、自分にぴったりのクリニックを見つけるところから始めてみましょう。
また、種類によってかかる費用・見た目の仕上がり・質感に違いがあります。
どの方法にもメリットやデメリットがあるため、予算やダウンタイムの有無をみながらしっかりと検討することが大切です。
この記事監修者
経歴・プロフィール
東京医科大学卒業(2004年)東京医科大学卒業後、麻酔科学講座入局。麻酔科退局後、 都内皮膚科・美容皮膚科院長として勤務。平成24年より医療法人容紘会高梨医院 皮膚科・ 美容皮膚科を開設。
![吉岡容子]()
グロウナビ編集部
日比野香
プロフィール
ゼロアクセル入社後、美容ジャンルを中心にディレクションを行なっています。美容施術が初めての方でも気軽に施術できるよう、わかりやすく記事執筆•ディレクションを行なっています。日本化粧品検定3級取得済み。